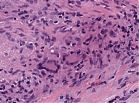
A42 Arteriitis temporalis

A42: Arteriitis temporalis
Histologie
- Organdiagnose: Arterie (Querschnitt)
- fibrinoide Nekrose – im Bereich der Intima-Media-Grenze mit Zerstörung der Lamina elastica interna
- Granulationsgewebe
- entzündliches Infiltrat
- Riesenzellen, die sich an Bruchstücke der Elastica interna lagern
Kurspräparat
Synonym: Riesenzellarteriitis temporalis Horton
Die Arteriitis temporalis lässt sich histologisch in drei Formen einteilen, die den verschiedenen zeitlichen Stadien der Erkrankung entsprechen dürften:
Klassifikation
- Klassische Form
- Intima-Media-begrenzte Myozytennekrose mit Zersplitterung der Lamina elastica interna
- mehrkernige Riesenzellen
- Umrahmung des Nekrosebezirks durch ein schütteres Granulationsgewebe
- Unspezifische Entzündungsform
- betrifft die ganze Gefäßwand
- beinhaltet ein dichtes Leukozyteninfiltrat
- Fibrosierende Form
- reaktive Intimafibrose
- Narben in der Lamina elastica interna & Media
Klinik
- stark erhöhte BSG und CRP
- pochende (Schläfen-) Kopfschmerzen, ev. Schmerzen beim Kauen
- verhärtete, druckschmerzhafte, eventuell pulslose A. temporalis
- Sehstörung bis hin zur Erblindung (bei Mitbeteiligung der A. ophthalmica)
- Ca. 60% der Patienten haben zusätzlich eine Polymyalgia rheumatica
Therapie
Schon bei dringendem Verdacht auf eine Arteriitis temporalis muss aufgrund der Erblindungsgefahr sofort mit einer Steroidbehandlung begonnen werden.
Prognose
Unbehandelt kommt es in ca. 30% der Fälle zu einer Erblindung. Rezidive treten bei rund einem Drittel der Patienten auf.
Bearbeiter:
Thomas Longerich
Letzte Änderung: 12.07.2024
Kurs Allgemeinpathologie

Bilder (3)

Abb. 457: Fibrinoide Nekrose mit Organisation und Zerstörung der Elastica interna
Abb. 458: Mehrkernige Riesenzellen (hohe Vergrößerung)
3 Entzündungslehre - Skript
- 3 Allgemeines zur Entzündungslehre
- 3.1 Akute Entzündung
- 3.2 Chronische Entzündung
- 3.3 Granulomatöse Entzündung
- 3.5 Tuberkulose
- 3.6 Immunpathologie
- 3.7 Regeneration und Wundheilung
- 3.7.1 Regeneration
- 3.7.2 Wundheilung
3.4 Immunpathologie - Weitere Kurspräparate
Related articles